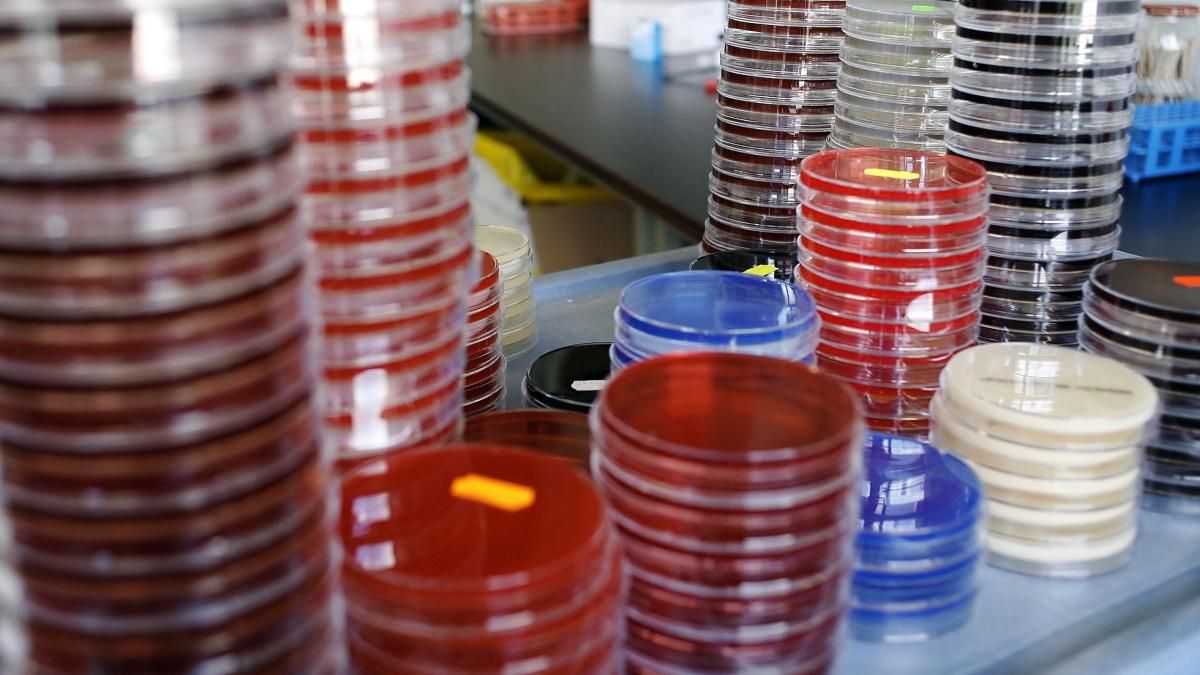

The following is an excerpt from Viruses, Pandemics, and Immunity by Arup K. Chakraborty and Andrey S. Shaw. Reprinted with Permission from The MIT PRESS. Copyright 2021.
Koch’s Postulates, Anthrax, Tuberculosis, and Cholera
Robert Koch was born in Germany in 1843. His father was a mining engineer. He taught himself to read by the time he was five years old, and was a brilliant student from a young age. After a brief time studying natural sciences in college, he decided to pursue a career in medicine. Koch held positions as a physician in various capacities in Poland, Berlin, and other places, including service as a doctor during the Franco-Prussian War. Koch also developed a deep interest in basic scientific research. Today, we would consider him a clinician-scientist, someone who tries to understand clinical aspects of diseases using basic scientific principles. Anthrax is a disease that affects both animals and humans, and was a problem in Koch’s time. Koch showed that, for a wide variety of animals, he could transfer disease from one animal to another by transferring blood from the infected animal to the healthy animal. All animals thus infected exhibited the same disease symptoms, and had the same rod-shaped bacteria in their blood. This convinced Koch that this specific bacterium caused anthrax. Koch’s work on anthrax was the first to associate a specific microbe with a particular disease.

It was known that healthy cattle got sick if they grazed on fields long after anthrax-infected cattle had grazed there. This was a puzzle because Koch had determined that anthrax bacteria in the blood of infected animals lost their infectivity after a few days. He decided that he would need to watch the bacteria over time and would need to develop methods to grow the bacteria in the lab. Koch developed methods to keep bacteria growing for days. This process is called “growing bacteria in culture” — “culture” refers to the medium in which the bacteria are grown. This method is now used millions of times every day around the world. When a doctor suspects that you have a bacterial infection, a small sample is collected from the suspected site of infection (e.g., a wound) and is sent to the pathology department. If the sample contains bacteria, they grow out in culture and can be identified. The doctor can use such a positive test result to prescribe the right treatment to kill the identified bacteria.
With the technique to culture bacteria in hand, using his careful observational skills, Koch noted that on occasion anthrax bacteria would convert into opaque spheres. He showed that these spheres could be dried and then reconstituted weeks later by immersing them into fluid. He suspected that the bacteria, if converted into the dry spheres, or spores, could remain dormant for years. Indeed, this is the case, and they can cause bacterial infection when ingested by uninfected cattle. Some readers will remember the anthrax scares in the United States right after the September 11, 2001, terrorist attacks when an individual placed anthrax spores into envelopes that were sent to members of the US Congress.
As Koch become more skilled in the identification of disease causing bacteria, his methods became codified into rules known as “Koch’s postulates”:
- The microorganism must be present in every instance of the disease.
- The microorganism must be isolated from a human with the disease and grown in culture.
- The microorganism grown in culture must cause the same disease upon injection in an animal.
- Samples from the animal in which disease thus occurs must contain the same organism that was present in the original diseased human.
These principles were applied successfully to determine the causative agents of many of the infectious diseases known today. Knowing the identity of specific bacteria that cause a particular disease, scientists and drug companies can develop antibiotics that can kill the bacteria and cure disease. Before the discovery of antibiotics, a small skin cut could get infected and result in death. We live in a world that would be unrecognizable to a nineteenth-century inhabitant because many previously lethal infections and diseases are easily treatable today.
Koch’s other significant discoveries were the bacteria that cause tuberculosis and cholera. Tuberculosis (TB) is a disease that has longed plagued the world. It was often called consumption, because it made the person look pale and thin as the disease progressed. In opera, it is the disease from which both Mimi in La Bohème and Violetta in La Traviata suffer, reflecting a nineteenth century association of romantic tragedy with this disease. TB caused enormous numbers of deaths in the nineteenth century. Since it is a contagious disease, it flourished partly because of the increased population density in growing cities during the industrial revolution. Throughout the nineteenth century, about one out of a 100 people living in New York City died of tuberculosis, roughly the same percentage as the number of reported COVID-19 deaths in the city and ten times more than die of influenza in an average year.
Until Koch showed that it was an infectious disease caused by bacteria, many thought that TB was an inherited disease. In 1882, using his postulates, Koch identified the causative organism and called it Mycobacterium tuberculosis. This discovery led to a better understanding of the disease and the development of TB-specific antibiotics, which along with better sanitation resulted in a significant decline in infections and deaths. However, TB is still widespread and remains a scourge in many parts of the world. In 2018 TB killed 1.5 million people globally. An especially worrisome development has been the recent emergence of antibiotic-resistant forms of M. tuberculosis. A vaccine that is used around the world to protect against TB infection has only limited efficacy.
Cholera is a waterborne disease that causes severe diarrhea and vomiting. Cholera outbreaks still cause havoc in the developing world today. The most recent outbreak of cholera was in Sudan in 2019. Another recent cholera epidemic was in Haiti in 2010 following a devastating earthquake. There are indications that, sadly, peacekeepers from the United Nations who came to provide aid may have inadvertently brought the disease to Haiti.
Koch received worldwide fame for his identification of the organism that causes cholera. However, the causative bacterium was, in fact, first described by an Italian physician, Filippo Pacini (1812–1883), many years earlier. During the period from the late 1810s to the early 1860s, there were worldwide cholera pandemics that started in India in the state of Bengal. Pacini was a doctor in Florence, Italy, when the pandemic spread into that city. Using a microscope to examine tissues collected during autopsies of those who had succumbed to cholera, Pacini discovered the bacterium, Vibrio cholerae, that causes the disease. Remarkably, few, including Koch, knew of his discovery, perhaps partly because the germ theory of disease was not widely accepted when Pacini described his observations. Better sanitation has made cholera a disease that is nonexistent in the developed world.
Koch, who passed away in 1910, received many significant recognitions for his work, including the 1905 Nobel Prize for Physiology and Medicine. We now turn to the work of his bitter rival, Louis Pasteur.
Pasteur, Rabies, and a New Paradigm for Vaccination
Pasteur was born in 1822 in France. His father was a tanner. Pasteur did not distinguish himself academically as a youngster. After earning a bachelor’s degree in philosophy in 1840, he was drawn to the study of science and mathematics. As is true today, in Pasteur’s time only the very best students in France were admitted to the École Normale Supérieure. Pasteur was ranked very poorly the first time he took the admission test, but he was ultimately admitted in 1843. This hiccup at an early stage of his scientific career did not prevent Pasteur from going on to make transformative discoveries.

When he was a professor at the University of Strasbourg, in France, Pasteur made a very important fundamental discovery which involved the mathematical concept of chirality. Two similar objects that have non-superimposable mirror images are chiral. The simplest example is our right and left hands — look at images of your hands in a mirror and you will see what we mean. While studying crystals of salts of certain acids, Pasteur demonstrated that molecules can also be chiral, either “right-handed” or “left-handed.” He developed a way to detect the handedness of such so-called optical isomers. A good example of handedness is sugar. Sugar is a chiral molecule that is right-handed, and sugar substitutes can be composed of its left-handed optical isomer. The molecule in our body that metabolizes sugar does not act on its left-handed isomer, and thus we do not metabolize it. But our taste buds cannot tell the difference between the right- and left-handed molecules, and so such sugar-substitutes would taste the same to us — a free lunch, so to speak.
Pasteur’s next big achievement was inventing a process which was later named pasteurization. One of Pasteur’s students was the son of a wine merchant, and he interested Pasteur into thinking about how to prevent wine from spoiling. It was commonly believed at the time that wine spoiled because it spontaneously decomposed into constituents that tasted like vinegar. Pasteur showed that this was not true and that a microbe called yeast was required to carry out these chemical transformations. Pasteur also showed that contamination of wine with various other microbes causes it to spoil. He invented a process to prevent this, which exploited the fact that microbes die at high temperatures. The wine was heated to about 120–140°F, and then sealed and cooled. Although this pasteurization process was invented to prevent wine from spoiling, it is rarely used for this purpose today. Rather, pasteurization is used all over the world to prevent milk from spoiling.
Pasteur also played a significant role in laying to rest the popular idea that many living organisms were spontaneously generated from nonliving matter. As old bread begins to grow mold and maggots suddenly appear in old meat, it wasn’t illogical to believe that these changes occurred spontaneously. Evidence against this so-called spontaneous generation theory had already been presented many times by other scientists, but Koch’s postulates and an elegant and definitive experiment that Pasteur did in 1859 finally proved to be its death knell. Pasteur stored boiled (pasteurized) water in two curved, swan-necked flasks. Boiling the water ensured that there were no microbes in it when the experiment was started. The construction of the swan-neck flask was such that microbes in the air would get stuck to the walls of the tube and not reach the water if the flask was vertically positioned. Pasteur positioned one flask vertically, and the other was tilted. As time passed, the water in the vertical flask did not show any signs of a developing biofilm (you must have seen such disgusting biofilms when you leave food in the refrigerator too long and microbes grow on it). A biofilm developed in the water in the tilted flask because microbes in the air could reach the water. This demonstration was the end of the spontaneous generation theory.
Most scientists can only dream of making contributions as important as Pasteur’s discovery of optical isomers, his invention of pasteurization, and his experiment ending the debate on the spontaneous generation of microbes. But his contributions to vaccination had such a major impact on humankind that the achievements described above have been completely overshadowed.
Pasteur’s paradigm-shifting advance in vaccine development was the result of a serendipitous observation he made while studying chicken cholera. On one occasion, after chickens were injected with the bacteria that causes this disease, they did not fall ill. On further investigation, Pasteur discovered that the batch of chicken cholera he had injected had spoiled. Rather than buy new chickens, he reinjected the first set of chickens with the properly cultured bacteria. To his surprise, the chickens did not fall ill. Pasteur is often credited with the famous remark, “In the field of observation, chance favors the prepared mind.” Pasteur’s mind was apparently prepared, as he immediately understood that he had stumbled on to an important finding. He realized that you could protect animals from infection with a live disease-causing microbe by vaccinating them with a weakened form of the same microbe.
This was a paradigm shift compared to previous methods. Variolation involved administering the real pathogen. Jenner’s use of cowpox involved finding a pathogen that was harmless to humans but related to the one that caused human disease. Pasteur’s new method did not involve hunting for a related harmless pathogen or risking the life of the patient by administering the real pathogen. Rather, a weakened or attenuated form of the pathogen could be used. It is worth remarking here that variolation involved powdering material from smallpox scabs and waiting a few days before administering it. These procedures were probably inadvertent ways to attenuate the virulence of the pathogen. But it was Pasteur who in the period between 1879 and 1880 formalized the procedure of using an attenuated pathogen to protect people from infectious diseases, and established a method that continues to be used today. Pasteur labeled his new method of protecting against various infectious diseases “vaccination,” in honor of Jenner’s use of vaccinia (cowpox) to protect against smallpox. Pasteur used his method to vaccinate birds to prevent cholera and vaccinate sheep to prevent anthrax.
Pasteur then developed a vaccine to protect against rabies. Rabies is an infection of the brain caused by the bite of an infected dog or, more often today, a bat. People infected with rabies exhibit symptoms like paralysis and fear of water. This fear of water is why the disease is sometimes called hydrophobia. Almost everyone afflicted with the disease died. Pasteur was a chemist and not a physician, but having successfully developed two animal vaccines, he was keen to use his skills to cure a human disease or protect people from it. We know today that rabies is caused by a virus, but the concept of a virus was not known at that time. Therefore, Pasteur could neither follow Koch’s postulates to identify the causative agent of the disease, nor grow the microbe in culture using methods that worked for bacteria. It was known, however, that the infectious agent was present in saliva. Pasteur is claimed to have been fearless, having used his mouth to suck on a glass tube to draw saliva from a rabid dog.
Using a method developed by his close collaborator, Emile Roux, Pasteur then attenuated the infectious agent. Pasteur and Roux administered the attenuated infectious agent and showed that multiple doses of this vaccine could protect dogs from rabies infection. Pasteur was anxious to try his vaccine in humans. He knew that the onset of symptoms usually lagged the dog bite by about a month. His idea was to vaccinate people soon after the dog bite, and hope that the protective mechanism (about which they knew nothing) would kick in quickly enough to cure them. The first two patients on whom this procedure was tried were in the late stages of the disease, however, and both died before they could receive the second dose of the vaccine. But Pasteur persevered.
In 1885, Joseph Meister, a 9-year-old boy living in Alsace, was bitten multiple times by a rabid dog that was subsequently shot by the police. His doctor learned that Pasteur had developed a vaccine to treat rabies. In an attempt to evade what was a certain death sentence, he brought Joseph and his family to Paris the next day to seek Pasteur’s help. Emile Roux refused to use the vaccine on Joseph as he worried that it was not ready for humans and was too dangerous to try on a child who did not yet have any symptoms of the disease. Pasteur found another physician to administer the treatment and it worked — the boy was cured. Subsequently, others would undergo the same procedure with similar success, and Pasteur became a hero. Years later, Meister, who was devoted to Pasteur, would serve as a caretaker at the Pasteur Institute.
Throughout this period, Pasteur worked on an anthrax vaccine even though Koch, who discovered the bacterium that causes anthrax, was also working on a vaccine. This led to terrible arguments between the two acclaimed scientists. Koch and his students wrote that Pasteur did not even know how to make pure cultures of bacteria. Pasteur fought back. These arguments took on an even more vicious tone during the Franco-Prussian War. In 1868, Pasteur had been awarded an honorary degree by the faculty of Bonn in Germany. He returned it during the war with an angry accompanying note. Thus began a division between German and French immunologists that would continue for decades, to the detriment of scientific advances. Pasteur ultimately achieved success in a public experiment in 1881 when he successfully vaccinated several sheep and cows, and a goat, to protect them from anthrax. He then declared it to be a great French victory. Ironically, an anthrax vaccine had earlier been developed by Jean Joseph Henri Toussaint (1847–1890) in France. Pasteur used the same method as Toussaint, but claimed that his approach was different.
When Pasteur died, he left his laboratory notebooks to his oldest male child, and his will stipulated that these notebooks should never leave the family and were to be passed on from generation to generation by male inheritors. In 1964, Pasteur’s last surviving direct male descendant donated his laboratory notebooks to the Bibliotheque Nationale in Paris. Scholars studying these notebooks found that Pasteur often cut corners in his work, sometimes did not describe exactly how experiments were done, and did not always publicly report results transparently. This straddling of ethical boundaries or, worse, fraud is severely punished by the modern scientific community. Indeed, as it should be, because the scientific edifice is built on the trust that scientists have described their studies honestly. Mistakes can happen, of course, but deceit is not allowed.
Pasteur’s straddling of ethical boundaries notwithstanding, he made groundbreaking advances that had a transformative effect. Vaccines designed using Pasteur’s methods have saved more lives than any other medical procedure. Vaccines that protect children from diseases are a major contributor to the dramatic reduction in childhood mortality. Today, we crave a vaccine against the ongoing COVID-19 pandemic, and hopefully, we will have one soon. Pasteur’s work is the foundation for this hope.
For his achievements, Pasteur received many honors and awards. Many streets around the world are named after him, and the Pasteur Institute in Paris is a famed medical research laboratory that Pasteur himself founded. He died in 1895, when he was 72, and his body is interred in the first floor of the original building of the Pasteur Institute. Visitors are welcome to see his tomb and the apartment where Pasteur lived at the end of his life. Pasteur did not receive a Nobel Prize because the first of these was awarded in 1901.